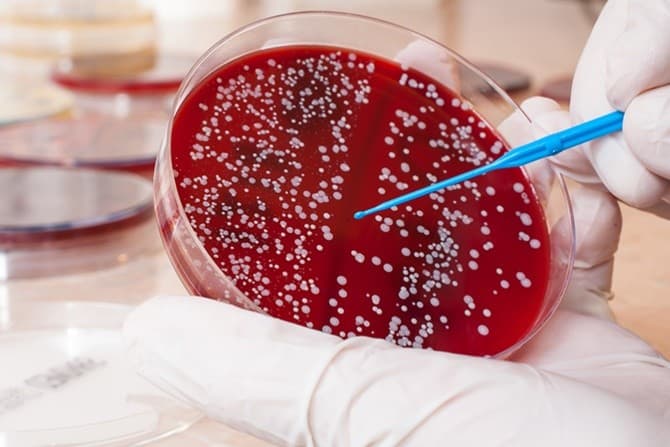
- Image

Kamis, 5 Maret
#kanker darah
Berita Terkini
Kesehatan
14 Oktober 2025, 17.44 WIB
Anak Terlihat Mudah Lelah dan Pucat? Waspadai Gejala Awal Leukemia Sejak Dini
14 Oktober 2025, 17.44 WIB
Kesehatan
05 Juni 2024, 02.55 WIB
Sembuhkan Kanker Darah Tanpa kemoterapi, Angka Harapan Hidup Pasien Semakin Tinggi
05 Juni 2024, 02.55 WIB
Kesehatan
22 April 2024, 20.57 WIB
Dokter Imbau Masyarakat Hindari Paparan Zat Asing Cegah Kanker Darah
22 April 2024, 20.57 WIB
Kesehatan
03 November 2023, 13.49 WIB
Kenali Gejala dan Risiko Multiple Myeloma, Jenis Kanker Darah yang Harus Diwaspadai Masyarakat
03 November 2023, 13.49 WIB

JawaPos.com adalah bagian dari Jawa Pos Group, perusahaan media terkemuka di Indonesia. Menyajikan berita terkini, akurat, dan terpercaya.
Graha Pena Lt.2 Jl. Raya Kby. Lama No.12, Grogol Utara, Kec. Kebayoran Lama, Kota Jakarta Selatan, Daerah Khusus Ibukota Jakarta 12210
021-53699659 | 021-5349207 (Fax)
- Nasional
- Kabinet Merah Putih
- Hijrah Ramadan
- Surabaya Raya
- Sepak Bola Indonesia
- Entertainment
- Berita Daerah
- Lifestyle
- Ekonomi
- Sports
- Internasional
- Jabodetabek
- Oto Dan Tekno
- Features
- Kesehatan
- Hobi & Kesenangan
- Opini
- Sisi Lain
- Ternyata Hoax
- Humaniora
- Sepak Bola Dunia
- Art Space
- Minggu
- Wisata Dan Kuliner
- Arsitektur Dan Desain
- Ibu Kota Baru
- Infrastruktur
- Zodiak
- Kepribadian
- Islami
- Parenting
- Kuliner
- Jawa Pos 75 Tahun
- Photo
- Hello Campus
©2026 PT JAWA POS GRUP MULTIMEDIA